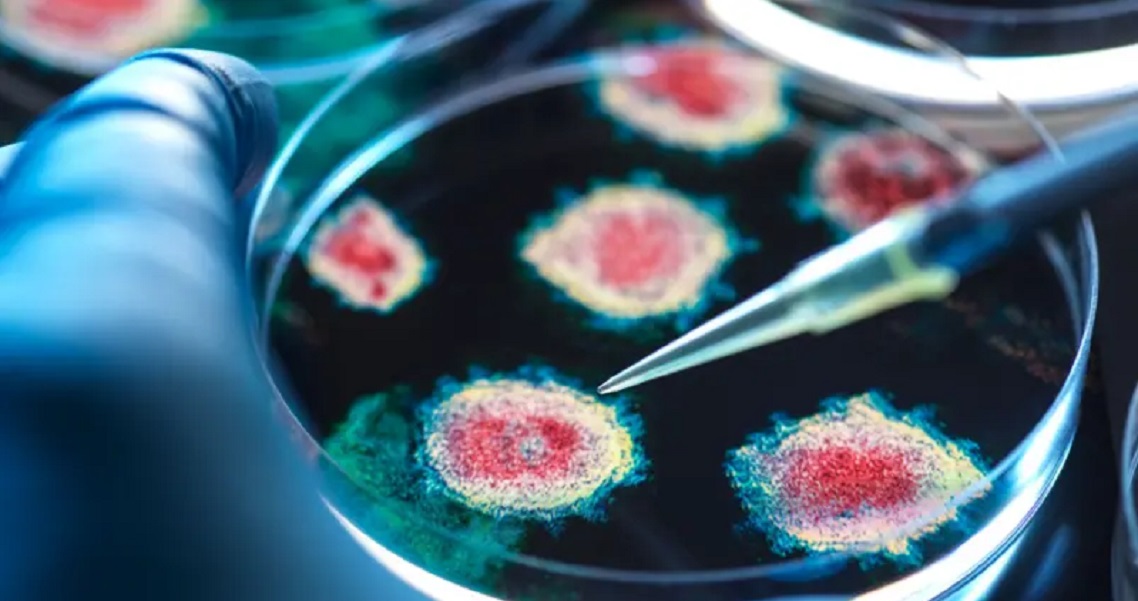

काठमाडौं ११ फागुन । चिनियाँ अनुसन्धानकर्ताहरूले चमेरोमा नयाँ कोरोनाभाइरस पत्ता लागेको बताएका छन् जसले कोभिड(१९ संक्रमण निम्त्याउने सार्स कोभ(२ ९क्ब्च्क् ऋयख्(द्द० भाइरसजस्तै काम गर्छ।
समाचार एजेन्सी रोयटर्सका अनुसार यो भाइरसले मानव शरीरमा प्रवेश गर्न सार्स कोभ(२ ले जस्तै कोष सतह प्रोटिन प्रयोग गर्छ।
कुनै दिन यो भाइरस मानिसहरूमा पनि फैलिन सक्छ कि भन्ने चिन्ता बढेको छ। तर चिनियाँ अनुसन्धानकर्ताहरूले यो नयाँ भाइरस सार्स कोभ(२ जत्तिकै सजिलै मानव शरीरमा प्रवेश नगर्ने बताएका छन्।
समाचार एजेन्सी पीटीआईले यो अध्ययनको नेतृत्व चिनियाँ वैज्ञानिक शि झेंगलीले गरेको बताएको छ, जसले विवादास्पद वुहान इन्स्टिच्युट अफ भाइरोलोजीमा पनि काम गरिसकेका छन्।
यो अध्ययन सेल नामक वैज्ञानिक जर्नलमा प्रकाशन भएको छ। यसमा यो नयाँ भाइरसको नाम एकेयू५(कोभ(२ ९ब्प्ग्छ(ऋइख्(द्द० भनिएको छ।
अमेरिकाले कोभिड(१९ भाइरस वुहानको यही प्रयोगशालाबाट उत्पन्न भएको आरोप लगाएको थियो। तर चीन सरकारले यो आरोप अस्वीकार गरेको छ।

प्रतिक्रिया दिनुहोस्